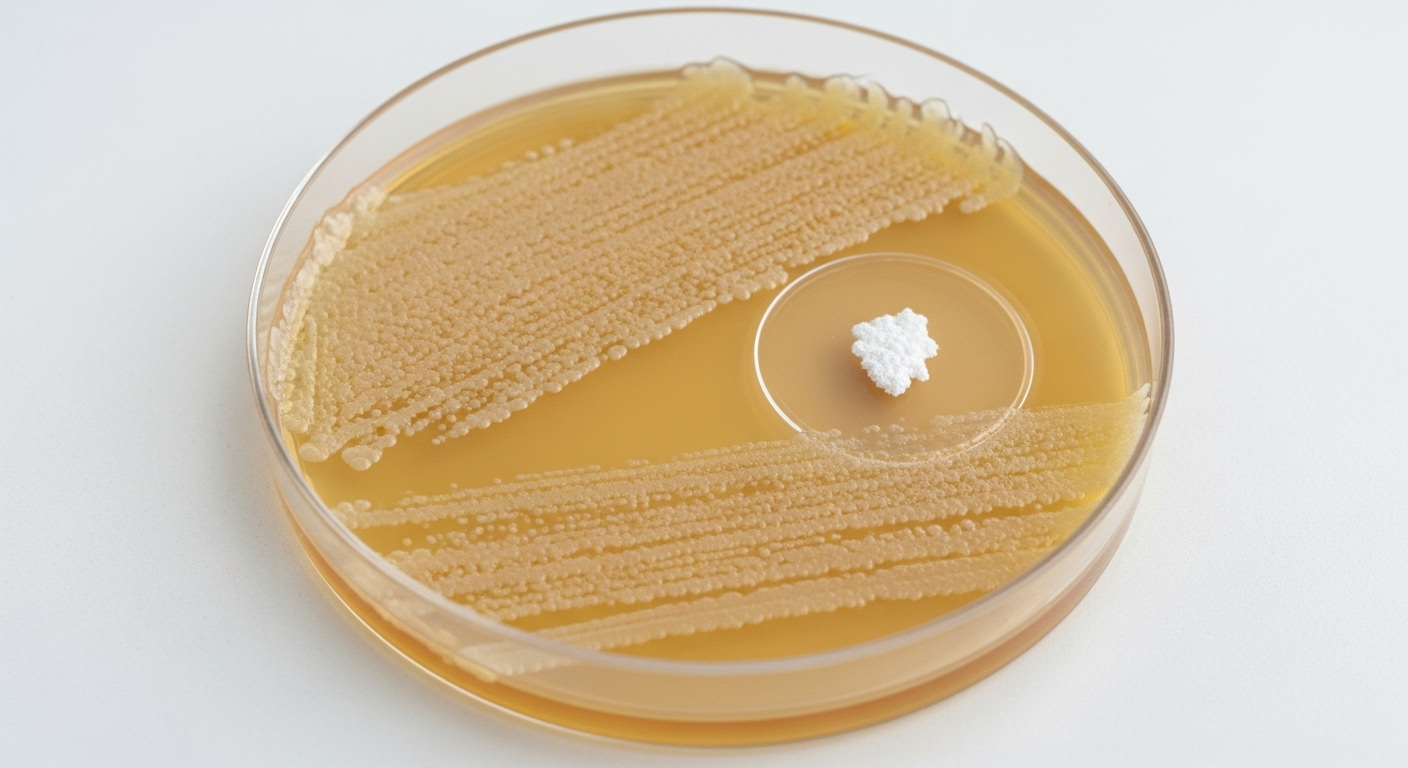
Un bouclier intégré contre les infections

Médecine : un dispositif expérimental imprime des greffes osseuses directement sur les fractures
Auteur: Adam David
L’image a de quoi surprendre : un chirurgien, au-dessus d’une fracture complexe, qui semble utiliser un simple pistolet à colle de bricolage. Loin de l’improvisation, cet outil modifié est en réalité une bio-imprimante 3D de pointe, capable de combler les lésions osseuses directement au bloc opératoire. Une équipe sud-coréenne a mis au point ce procédé qui pourrait bien simplifier radicalement la chirurgie réparatrice.
Le casse-tête des fractures complexes

Normalement, l’os est un champion de l’auto-réparation. Mais face à une fracture trop large, ou après l’ablation d’une tumeur, le corps a parfois besoin d’un coup de pouce. Les solutions actuelles ont leurs limites. Les greffes de donneurs ? Précieuses, mais rares et non sans risque de rejet. Les implants métalliques ou en polymères ? Ils comblent le vide, mais ne s’intègrent pas toujours parfaitement, ce qui peut fragiliser la reconstruction sur le long terme.
L'impression 3D, une solution encore imparfaite

L’impression 3D a déjà changé la donne, en permettant de créer des implants sur mesure, parfaitement adaptés à la morphologie du patient. Mais le processus reste lourd. Il faut une imagerie précise de la fracture, modéliser l’implant, l’imprimer en laboratoire dans des conditions stériles, puis le transporter… Tout cela prend du temps et coûte cher, un luxe que l’on n’a pas toujours en chirurgie d’urgence.
L'idée qui change tout : imprimer directement sur le patient

Alors, pourquoi ne pas sauter toutes ces étapes ? C’est le pari de l’équipe de l’Université Sungkyunkwan. Leur idée : apporter l’imprimante au patient, et non l’inverse. « Notre système permet de fabriquer et d’appliquer le support en temps réel, directement sur le site chirurgical », explique le professeur Jung Seung Lee, co-auteur de l’étude. Fini les problèmes d’ajustement : le matériau épouse parfaitement la forme de la lésion, même la plus irrégulière, en quelques minutes seulement.
Un biociment intelligent et biodégradable

Le secret réside dans l’« encre » utilisée par ce pistolet. Un mélange de deux ingrédients clés : l’hydroxyapatite, un minéral naturellement présent dans nos os qui favorise leur régénération, et le polycaprolactone (PCL), un polymère biocompatible qui devient malléable autour de 60 °C. N’est-ce pas trop chaud ? Non, car le matériau refroidit juste assez vite au contact de l’os pour ne causer aucune brûlure, tout en restant assez souple pour s’insinuer dans la moindre anfractuosité. Cerise sur le gâteau, cet implant est conçu pour se dégrader lentement, laissant la place à l’os neuf qui repousse.
Un bouclier intégré contre les infections
L’autre hantise des chirurgiens orthopédiques, c’est l’infection post-opératoire. Pour parer à ce risque, les chercheurs ont enrichi leur matériau avec deux antibiotiques, la vancomycine et la gentamicine. Diffusés localement et sur plusieurs semaines, ils agissent comme un bouclier là où on en a le plus besoin. C’est une approche bien plus ciblée que l’administration d’antibiotiques par voie générale, qui peut avoir des effets secondaires et contribuer à l’antibiorésistance.
Des résultats prometteurs sur des modèles animaux

La théorie est séduisante, mais qu’en est-il en pratique ? L’équipe a testé son dispositif sur des lapins de Nouvelle-Zélande présentant des fractures sévères du fémur. Certains ont reçu l’implant bio-imprimé, les autres un ciment osseux classique. Douze semaines plus tard, le verdict était sans appel : les lapins du premier groupe montraient une guérison osseuse bien meilleure, avec une densité et une surface osseuse supérieures. Et surtout, aucune trace d’infection ou de nécrose n’a été observée.
vers une application en clinique ?

Le chemin vers les blocs opératoires humains est encore long. Il faudra encore valider la technique sur de plus grands animaux et mettre en place des protocoles de fabrication et de stérilisation irréprochables. Mais si ces étapes sont franchies, on pourrait bien assister à une petite révolution, transformant la réparation osseuse en un acte plus rapide, plus sûr et véritablement sur mesure, réalisé en direct sous les yeux du chirurgien.
Selon la source : trustmyscience.com










